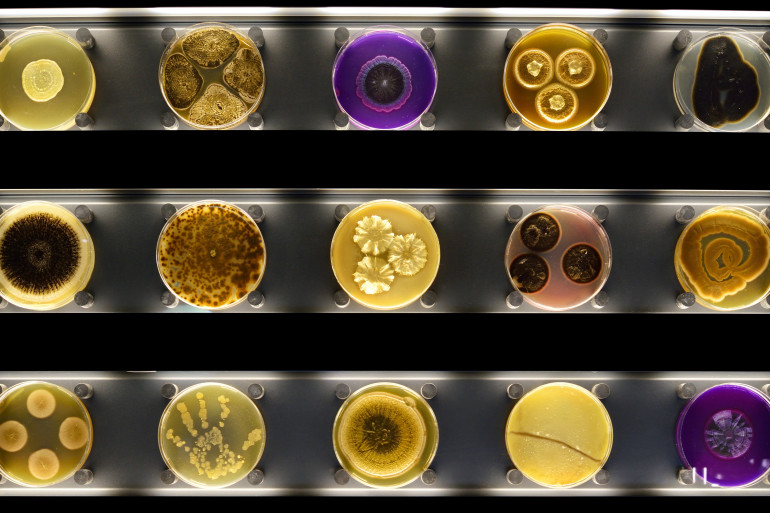

2 min de lecture
Pays-Bas : ouverture du premier zoo à microbes au monde
Mardi à Amsterdam, un zoo très particulier à ouvert ses portes, Micropia. Il s'agit du premier au monde à mettre à l'honneur les microbes.
Souvent associés aux maladies, les microbes sont en fait essentiels à la survie de l'homme (illustration).
Crédit : AFP PHOTO/MICROPIA/MAARTEN VAN DER WAL
Je m'abonne à la newsletter « Infos »
Et si les zoo traditionnels ne montraient qu'une infime partie de la nature ? Le premier "zoo interactif à microbes" au monde a ouvert ses portes à Amsterdam mardi, il met à l'honneur ces minuscules créatures qui constituent deux tiers des organismes vivants sur la Terre.
Ce zoo particulier dans lequel est exposée une vaste collection de microbes a été imaginé par le directeur du zoo royal d'Amsterdam, Artis. Douze ans et 10 millions d'euros après la naissance de l'idée, c'est à côté d'Artis que "Micropia" a été installé.
"Les zoos ont tendance à ne montrer qu'une partie de la nature, à savoir les grands animaux", assure le directeur du zoo Artis : "aujourd'hui, nous voulons montrer la micro-nature".
1,5 kg de microbes sur le corps
Pour lui, l'importance des microbes a toujours été sous-estimée depuis leur observation au XVIIème. En effet, les virus, mycètes et autres bactéries sont souvent associés aux maladies. Mais en réalité, ils sont aussi essentiels pour notre survie et joueront un rôle de plus en plus important pour l'avenir de l'humanité et de la planète.
Chaque humain adulte compte environ 1,5 kilogramme de microbes dans son corps, sans lesquels il mourrait.
La plus grande partie du zoo, qui dit être le premier du genre au monde, ressemble à un laboratoire. Plusieurs rangées de microscopes reliés à des écrans géants montrent toutes sortes de micro-organismes.
Passer au scanner à microbes
Le visiteur peut observer à travers une fenêtre un vrai laboratoire dans lequel différentes sortes de microbes sont cultivés ou encore se retrouver face à un modèle géant du virus Ebola, qui ravage actuellement l'Afrique de l'Ouest.
Il est également possible d'observer des microbes se reproduire grâce à un microscope 3D spécialement développé pour le zoo ou encore de passer au scanner à microbes, qui indiquera au visiteur combien d'entre eux vivent sur lui, et où.
Les plus amoureux pourront s'embrasser devant le "Kiss-o-Meter" qui indique combien de microbes ont été échangés sur la durée du baiser.




